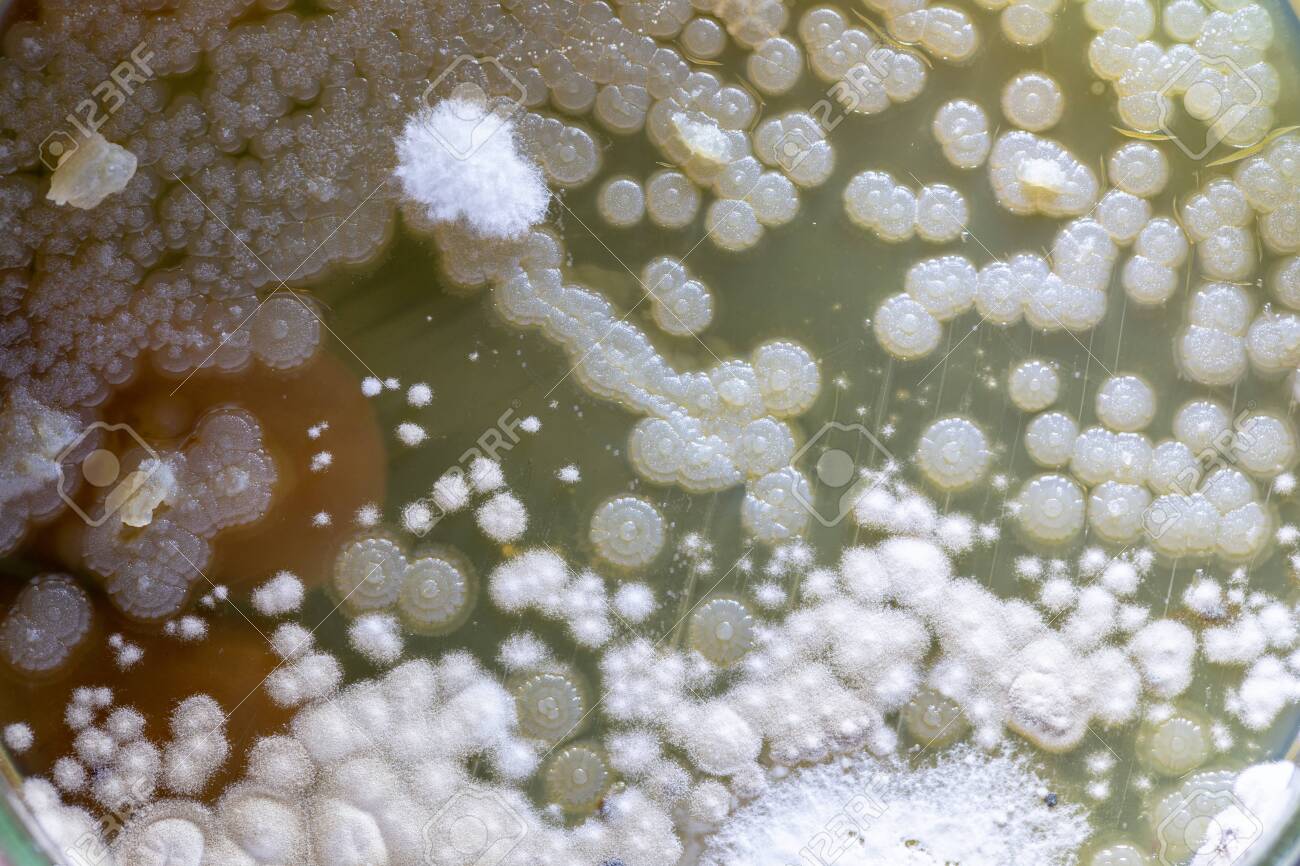

Download
Close
Автор:
id:
Ключевые слова:
actinomyces, agar, analysis, background, bacteria, bacterial, bacterium, biology, biotechnology, characteristic, colony, culture, danger, disease, dish, education, environment, equipment, experiment, food, fungi, germs, growing, growth, health, health care, hygiene, identification, isolated, lab, laboratory, medical, medicine, micro, microbial, microbiology, microorganism, mold, molds, organism, pattern, petri, plate, research, risk, safety, sample, samples, science, shape, soil samples, species, texture, white, yeast,